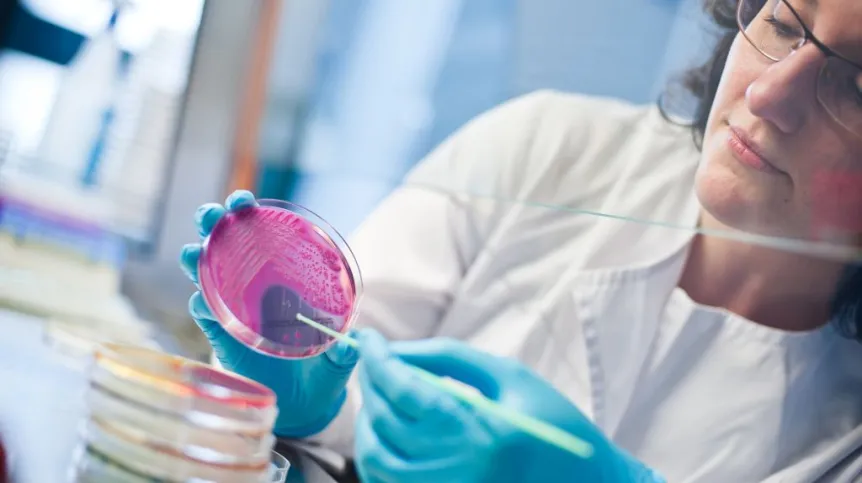

Quick and inexpensive identification of bacteria, for example in animals, with up to 98 percent accuracy is the task of Polish diagnostic robot - Bioavlee. The device can contribute, for example, to minimizing the problem of prophylactic administration of antibiotics to animals.
"The data on the use of antibiotics in the industry, medicine and veterinary medicine are alarming. In the United States, about 80 percent of all antibiotics are administered to healthy animals, prophylactic antibiotics are sometimes used even in the cultivation of apples. All this to fight bacteria that could threaten crops, livestock or health of humans and animals. Prophylactic use of antibiotics could be minimized by introducing a cheap and quick method for identifying bacteria" - said Dr. Damian Andrzejewski of the Polish company Bioavlee.
The minimization of this phenomenon may be easier with the Polish diagnostic robot - Bioavlee. This compact device can be used by anyone after just a few minutes of training. The sample (taken from the skin, ear, eye, etc.) is easily placed in the machine that is engaged by pressing a button on the display and, without further human involvement, performs processes leading to the identification of bacteria present in the sample. The method uses a laser beam, recording of spectra, patented optical system and computer image analysis.
"Our solution is simple to use and does not require the involvement of qualified personnel. Just prepare the sample, which then goes into the machine. After several hours, test results are sent to the client" - said Marcin Bruś of Bioavlee.
"Our method combines traditional bacterial culture with astonishing speed of laser diffraction and artificial intelligence. Pattern images of spectra are stored in the cloud, and our database continues to grow. As a result, we are now able to identify bacteria with an accuracy of up to 98 percent. Importantly - it is done within 9 to 16 hours after inoculation, and the bacteria identification - after the culturing - actually only takes a few seconds" - explained Dr. Damian Andrzejewski.
Microbiological tests are now used in veterinary medicine. But because of limited budget, time and limited access to research facilities manufacturers often choose prophylactic use of bactericidal antibiotics instead of testing.
The method and device will benefit companies and institutions that use microbiological tests on a daily basis - for example in order to carry out effective drug therapy or to assess the microbiological purity of the collected material. The solution may be of interest to veterinary clinics, and over time also the industry and laboratories.
The device will be available to customers on a subscription basis. According to its creators, tests carried out with the robot will be several times cheaper than those carried out using other methods. Currently, the robot is being tested in production plants in Switzerland and Poland. The planned commercialisation of the device is expected to begin next year.
PAP - Science and Scholarship in Poland
ekr/
tr. RL













